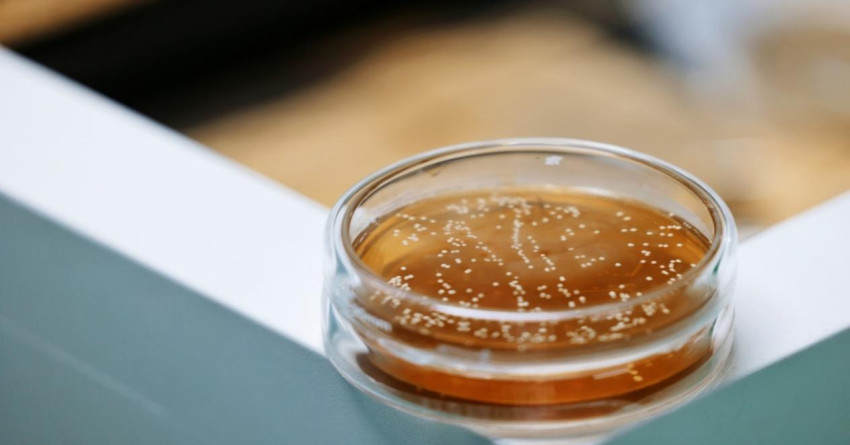

凭借地道贵州风味脱颖而出,苗苗酸汤成台江县苗族姊妹节唯一酸汤供应商
红餐编辑部 · 2026-04-29 13:45:31 来源:红餐网 496
红餐网消息,4月30日至5月10日,2026年苗族姊妹节将在贵州台江县隆重举行。作为苗族的盛大传统节日,苗族姊妹节早在2006年就被列入第一批国家级非物质文化遗产名录,具备较强的社会文化影响力。
自举办以来,台江县的苗族姊妹节也受到了年轻人的热捧,越办越热闹,形成了包括万人盛装游演、情歌对歌、长桌宴等在内的多种节日活动,每年都会吸引众多民众参与。

△图片来源:澄明食品
另据红餐网了解,今年的台江县姊妹节将于5月1日和5月2日分别在台江县民族团结广场及姊妹广场两侧举办长桌宴。为展示出苗族最高接待礼仪,和营造出民族团结的氛围,长桌宴每日约设置500桌、分早晚两场,预计每日接待4000人,总计覆盖近万人次,规模不小。
值得关注的是,台江是天下苗族第一县,苗族人口占比高达98%。众所周知,酸汤是苗族的饮食文化符号,因此酸汤也成为此次长桌宴不可或缺的一道地域特色美食。为了让这份地道风味精准传递给每一位活动参与者,选择一个兼具品质与口碑的酸汤品牌至关重要。
基于这样的考量,红餐网获悉,台江县苗苗酸汤食品有限公司(下文简称苗苗酸汤)凭借地道的贵州基因,成为今年苗族姊妹节酸汤锅底的唯一供应商,将在此次活动中隆重登场。

△图片来源:澄明食品
公开资料显示,苗苗酸汤位于贵州台江县台盘村,是一家集苗家酸汤研发、生产、销售于一体的科技创新型食品企业,由锅圈食品(上海)股份有限公司与中国农科院农产品加工研究所在2024年共同投资1亿元成立。
据了解,苗苗酸汤产品在配方上主打“零添加、零色素、零防腐剂”的健康特色,同时原料的使用也颇为讲究,精选贵州本地小番茄(毛辣果)、高山小黄姜、苗岭土辣椒等优质原料,精准提取传统酸汤的醇厚鲜香,使得产品酸辣层次丰富,口感绵长,契合长桌宴对地道风味与品质的双重要求。
除品质口感外,苗苗酸汤产品在使用上还主打极简百搭。据了解,苗苗酸汤产品使用时仅需按照1:4比例加入清水,无需复杂调味,再搭配肉类、河海鲜以及豆腐、蔬菜等多种食材,就能轻松打造出苗家酸汤鱼、酸汤牛肉火锅等地道美味,适配长桌宴场景的便捷餐饮需求。

△图片来源:澄明食品
对于此番深度参与苗族姊妹节这一苗族文化IP盛事,澄明食品表示,这将助力品牌实现权威背书与大众声量的双重突破,意义重大。不仅能深化与当地政府及体旅集团的合作,借助政企协同赋能,提升公司在当地的美誉度,还能依托节庆期间的海量人流直接触达1.2万人次,有效扩大品牌知名度。
近年来,苗苗酸汤还在生产工艺上不断发力。比如将中国农科院农产品加工所三项专利技术与贵州千年非遗酸汤工艺进行了深度融合,通过传统技艺与现代科技的双向赋能,助力现代化“酸汤+N”食品生产。
不仅如此,苗苗酸汤还创新研发出“七天智能发酵”工艺,依托专利菌种技术,从26份非遗酸汤样本中精准筛选出核心菌株,成功突破传统酸汤长达半年的发酵周期,实现7天快速发酵,使得发酵效率提升超90%。
△图片来源:澄明食品
除生产工艺外,苗苗酸汤还致力于生产基地建设。据了解,苗苗酸汤目前在贵州台江县已经拥有2万平方米现代化生产基地,且全部使用现代化生产车间及生产线,配备6×22吨智能发酵罐集群,一期年产能达1.2万吨,具备稳定的产品交付能力。
值得一提的是,苗苗酸汤还与河南鹿邑澄明食品、四川广元澄明食品并列,共同构成锅圈供应链旗下澄明食品的三大生产基地,这也标志着澄明食品正式迈入三工厂发展阶段,实现了品牌战略的重大升级。升级之后,澄明食品可实现三大生产基地协同发力,以夯实复调品类壁垒,持续完善全国产能布局。
总体而言,苗苗酸汤此番深度参与苗族姊妹节这一非遗文化盛会,以过硬产品品质将贵州酸汤深厚的文化底蕴与独特魅力,清晰呈现在全国消费者面前,充分彰显了其在酸汤锅底赛道的领先优势,是品牌综合实力获得市场认可的生动体现。未来苗苗酸汤还会如何布局发展,红餐网将持续关注。
作者:红餐网桂湘;编辑:李唐




















写评论
0 条评论